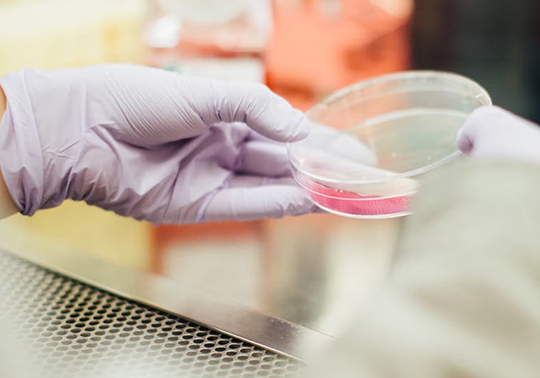

Segundo plazo de la Convocatoria 2026 de la Consellería de Educación, Cultura, Universidades y Ocupación para la promoción de la investigación científica, el desarrollo tecnológico y la innovación en la Comunidad Valenciana, para el ejercicio 2025.
|
Por RESOLUCIÓN de 27 de junio de 2025, por la cual se convocan, para el ejercicio 2026, subvenciones del Programa para la promoción de la investigación científica, el desarrollo tecnológico y la innovación en la Comunidad Valenciana. Esta convocatoria recoge la regulación, mediante anexos, de diferentes subvenciones de los siguientes subprogramas:
|
|
Plazo equipo de trabajo* |
Plazo interno solicitud* |
Plazo registro* |
Contacto |
Webinari |
|
|
Anexo I : ACIF |
21/11/2025 |
||||
|
Anexo II: BEFPI |
28/07/2025 |
||||
|
Anexo III: GRISOLIA |
28/07/2025 |
||||
|
Anexo IV: APOSTD |
21/11/2025 |
||||
|
Anexo VI:APOTI |
28/07/2025 |
||||
|
Anexo VII: AEST |
|
21/11/2025 |
|||
|
Anexo VIII: BEST |
28/07/2025 |
||||
|
Anexo IX: GE |
|
19/11/2025 |
21/11/2025 |
23/10/2025 de 9:30 a 11:30 - Accés sessió |
|
|
Anexo X: AICO |
|
19/11/2025 |
21/11/2025 |
24/10/2025 de 9:30 a 11:30 - Accés sessió |
|
|
Anexo XI: PROMETEO |
|
19/11/2025 |
21/11/2025 |
24/10/2025 de 12:00 a 14:00 - Accés sessió |
|
|
Anexo XII: APE |
21/11/2025 |
||||
|
Anexo XIII: AORG |
25/07/2025 |
28/07/2025 |
10/07/2025 de 12:00 a 14:00 |
* Todos los plazos se consideran fechas límite y hasta las 14.00 del dia señalado.
Puede encontrar más información sobre este tema en los siguientes enlaces:
(Para acceder a la última versión de los documentos, considerando que es una convocatoria recurrente. les rogamos que utilicen las teclas “CTRL+F5” después de abrir esta página web).








